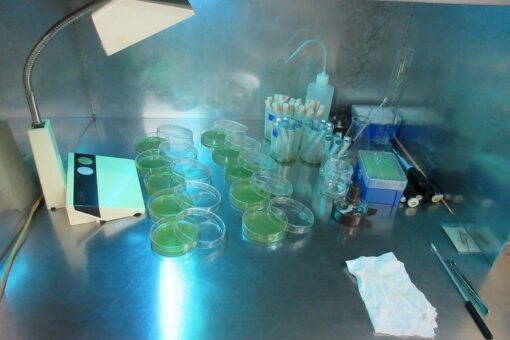

【生物工学科】秦野教授のラオス通信#10
秦野教授のラオス通信もついに10回目になってしまいました。 まだ続くのでしょうか?
PCR検査
9日目(8/30)は、朝からPCR検査です。 今日(9/7)からは不要になったのかもしれませんが、この時はまだ日本に入国する前72時間以内のPCR陰性証明がないと、帰れない状態でした。 ですのでこの日は朝8:30から検査場に行きました。

厚生省の疾病研究所のようなところで検体を集めていました。 私はちょっと早めと思って8:30には着いたのですが、すでに長蛇の列。 仕方なく並んでしばらくして後ろを見ると・・もっと多くの人が・・! ちょっと甘く見ていました。 列のほとんどは中国人です。 中国語に浸っていました。 パスポートの色を見ると目が届く範囲で4種類くらい見えたので、中国に行く人か日本に行く人なんだろうと思いました。

1時間以上並んで、9:35にやっと私の番が来ました。 鼻とのどの両方の検体を採取されました。 費用は約50$。 結構高い。 結果は今日の16;00過ぎに出るのですが、その書類の受け取りはシハッタさんにお願いして、私は井上さんと一緒に、LAODIの工場に戻ることとしました。

再びLAODIへ
LAODIでは、日本向けのボトルの詰め込み作業が行われていました。 寝かせていた原酒をタンクからくみ出して、まずフィルターろ過します。

そして清澄になった原酒のアルコール濃度を測定して(ここでは蒸留した200 mL分のエタノール(15℃まで冷やして)を酒精計で測ってエタノール濃度を計算していました。 この計算、本当は結構ややこしいんですよ)、商品のアルコール度数ごとに加水の量を決めていました。

数日前に仕入れた新しいビンもみんなできれいに洗っています。 これを乾燥させて新しい酒を詰めるのです。

もちろん使ったフィルタープレスも毎日分解してきれいに洗って、一日が終わります。

このころ、私のPCRの結果(鼻、のどとも陰性)がシハッタさんから写真で送られてきました。 やれやれです。
ラボで実験
井上さんは新しいシャーレの培地(平板)を作っています。 クリーンベンチではないけど紫外線を当てているから、ふたを少し開けて乾かしてみようと私の提案でそうしてみたら・・これは見事に失敗でした。 関空に着いたとたんに、井上さんからラインが届いて、カビだらけになっていました。 やっぱり外向きに風が流れていないと、中がクリーンにならないのですね。 失敗、失敗・・作り直してね(>〇<)
シャーレを乾かしている間に、熟成樽を保管している倉庫をのぞいてみました。 2019年の12月よりかなり数が増えていました。 美味しいラム酒ができますように・・。

実はこの中に私の樽も一つ眠っているのですよ(写真は見にくいですが)。 私の卒業の時の記念品しようと思っています。

明日は最終日です。




